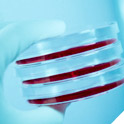
clinical
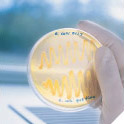
food & beverage

Call Us At (800) 682-2666 | Fax (800) 968-9494
Home Page
Why PML Microbiologicals
PML Microbiologicals is committed to the highest quality standards as reflected in our Quality Policy. PML takes pride in being an FDA registered and ISO 13485:2003 certified manufacturer. All of our facilities strictly adhere to the standards and requirements of the cGMP, CLSI, and USP in the production and testing of our products. Companies in highly regulated industries, such as pharmaceutical production, perform facility audits and manufacturer qualification reviews of PML on a regular basis.
Our customers agree that the quality of PML products results from a stringent quality assurance program that has been an integral part of the PML culture since PML was founded in 1969. In a recent satisfaction survey, PML customers consistently listed "Product Quality" as one of our company's best attributes.
PML Microbiologicals’ mission is to manufacture and supply products that support the prevention, diagnosis and treatment of disease. We strive to provide the highest levels of service and quality to scientific customers worldwide. Through managed growth, financial strength, and a supportive work environment, we deliver value to our investors, achieve excellence in our jobs, and share success with our communities.
PML Microbiologicals produces products that are used in a wide variety of industries ranging from hospital laboratories to pharmaceutical drug manufacturing facilities. Our products touch lives, directly or indirectly, in many different ways. We understand that the safety of the people relying on your results depends on the integrity of our products and PML takes this responsibility very seriously. Our rigorous quality control program ensures that you will see consistent quality and product performance each and every time.
IMPORTANT UPDATE
Products changing catalog numbers and New remittance address
Effective May 1, 2009, some of our products will have new catalog numbers. See 2nd page of the attached letter for a list of products.
Also effective this date, please note the following changes for remittance. Click here for more details.
bioMérieux, Inc.
PO Box 500308
St. Louis, MO 63150-0308
clinical
clinical
 pharmaceutical & biotechnology
pharmaceutical & biotechnology
food & beverage
food & beverage
 environmental
environmental
 molecular research
molecular research